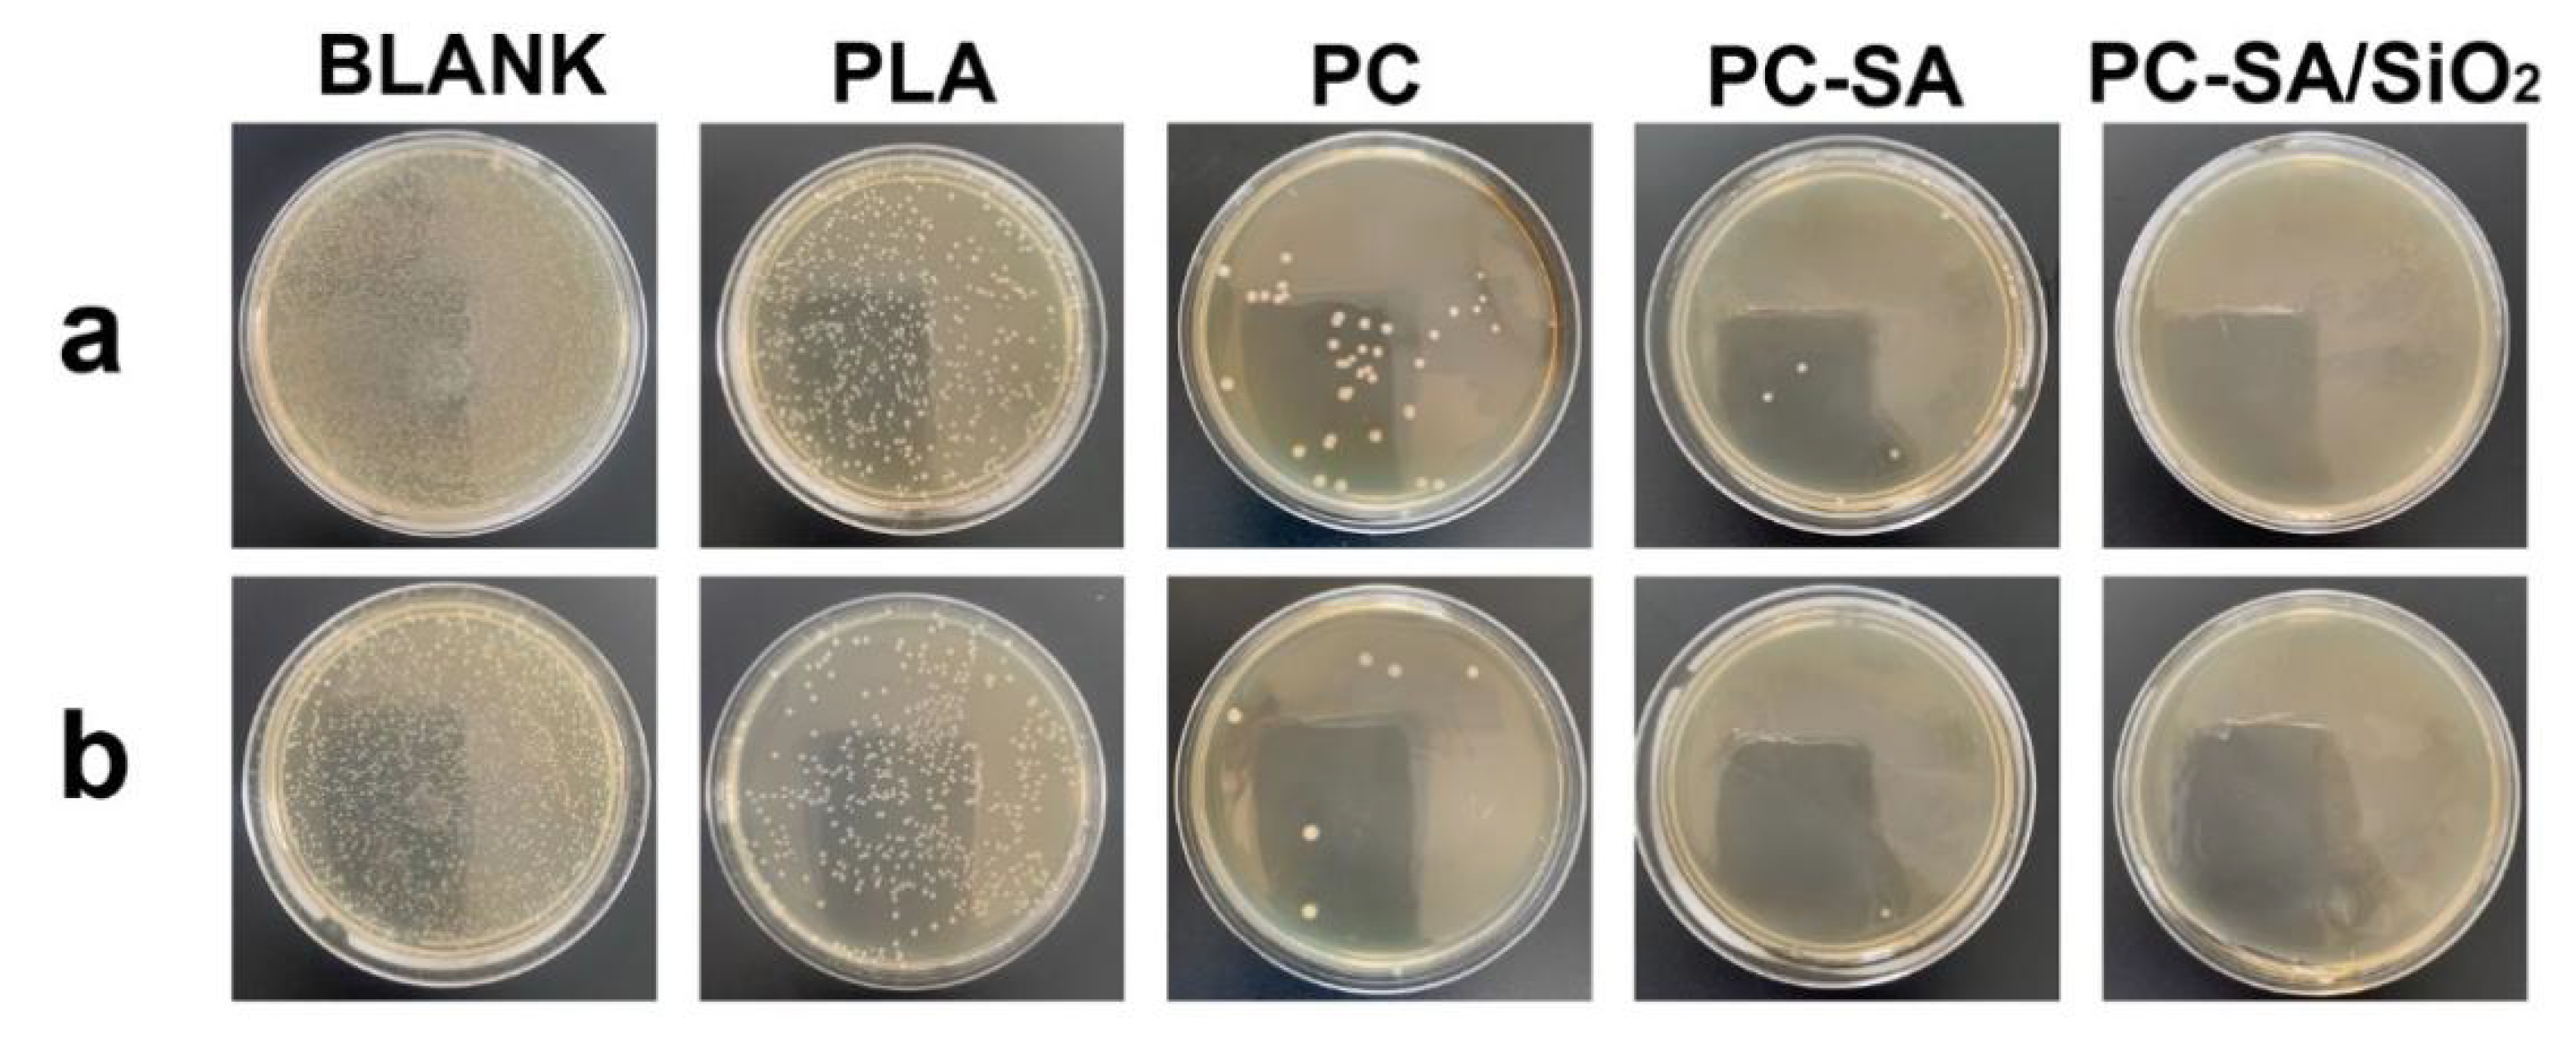
Ijms 23 11158 g007 550

Preparation and Characterization of Degradable Cellulose−Based Paper with Superhydrophobic, Antibacterial, and Barrier Properties for Food Packaging
Abstract
:1. Introduction
2. Results and Discussion
2.1. FT−IR Analysis
2.2. Thermal Stability and Mechanical Properties
2.3. SEM and Superhydrophobic Properties
2.4. Barrier Performance
2.5. Antibacterial Properties
3. Materials and Methods
3.1. Materials
3.2. Sample Preparation
3.3. Characterization Techniques
3.4. Barrier Properties
3.5. Antibacterial Efficacy
4. Conclusions
Supplementary Materials
Author Contributions
Funding
Institutional Review Board Statement
Informed Consent Statement
Data Availability Statement
Conflicts of Interest
References
- Samantaray, P.K.; Little, A.; Wemyss, A.M.; Iacovidou, E.; Wan, C. Design and control of compostability in synthetic biopolyesters. ACS Sustain. Chem. Eng. 2021, 9, 9151–9164. [Google Scholar] [CrossRef]
- Diggle, A.; Walker, T.R. Implementation of harmonized extended producer responsibility strategies to incentivize recovery of single-use plastic packaging waste in Canada. Waste Manag. 2020, 110, 20–23. [Google Scholar] [CrossRef]
- Ding, R.; Tong, L.; Zhang, W. Microplastics in freshwater environments: Sources, fates and toxicity. Water Air Soil Pollut. 2021, 232, 5. [Google Scholar] [CrossRef]
- Vethaak, A.D.; Legler, J. Microplastics and human health. Science 2021, 371, 672–674. [Google Scholar] [CrossRef] [PubMed]
- Samantaray, P.K.; Little, A.; Haddleton, D.M.; McNally, T.; Tan, B.; Sun, Z.; Huang, W.; Ji, Y.; Wan, C. Poly (Glycolic acid) (PGA): A versatile building block expanding high performance and sustainable bioplastic applications. Green Chem. 2020, 22, 4055–4081. [Google Scholar] [CrossRef]
- Huang, X.; Luo, X.; Liu, L.; Dong, K.; Yang, R.; Lin, C.; Song, H.; Li, S.; Huang, Q. Formation mechanism of egg white protein/κ-carrageenan composite film and its application to oil packaging. Food Hydrocoll. 2020, 105, 105780. [Google Scholar] [CrossRef]
- Wu, C.; Sun, J.; Zheng, P.; Kang, X.; Chen, M.; Li, Y.; Ge, Y.; Hu, Y.; Pang, J. Preparation of an intelligent film based on chitosan/oxidized chitin nanocrystals incorporating black rice bran anthocyanins for seafood spoilage monitoring. Carbohydr. Polym. 2019, 222, 115006. [Google Scholar] [CrossRef]
- Shu, L.; Zhang, X.F.; Wang, Z.; Yao, J. Structure reorganization of cellulose hydrogel by green solvent exchange for potential plastic replacement. Carbohydr. Polym. 2022, 275, 118695. [Google Scholar] [CrossRef]
- Li, H.; He, Y.; Yang, J.; Wang, X.; Lan, T.; Peng, L. Fabrication of food-safe superhydrophobic cellulose paper with improved moisture and air barrier properties. Carbohydr. Polym. 2019, 211, 22–30. [Google Scholar] [CrossRef] [PubMed]
- Rhim, J.W. Effect of moisture content on tensile properties of paper-based food packaging materials. Food Sci. Biotechnol. 2010, 19, 243–247. [Google Scholar] [CrossRef]
- Andersson, C. New ways to enhance the functionality of paperboard by surface treatment—A review. Packag. Technol. Sci. 2008, 21, 339–373. [Google Scholar] [CrossRef]
- Qiang, T.; Wang, J.; Wolcott, M.P. Facile fabrication of 100% bio-based and degradable ternary cellulose/PHBV/PLA composites. Materials 2018, 11, 330. [Google Scholar] [CrossRef] [PubMed]
- Bodbodak, S.; Shahabi, N.; Mohammadi, M.; Ghorbani, M.; Pezeshki, A. Development of a novel antimicrobial electrospun nanofiber based on polylactic acid/hydroxypropyl methylcellulose containing pomegranate peel extract for active food packaging. Food Bioprocess Technol. 2021, 14, 2260–2272. [Google Scholar] [CrossRef]
- Liu, Y.W.; Liang, X.; Wang, S.Y.; Qin, W.; Zhang, Q. Electrospun antimicrobial polylactic acid/tea polyphenol nanofibers for food-packaging applications. Polymers 2018, 10, 561. [Google Scholar] [CrossRef]
- Taboada-Rodriguez, A.; Garcia-Garcia, I.; Cava-Roda, R.; Lopez-Gomez, A.; Marin-Iniesta, F. Hydrophobic properties of cardboard coated with polylactic acid and ethylene scavengers. J. Coat. Technol. Res. 2013, 10, 749–755. [Google Scholar] [CrossRef]
- Wang, X.; Tang, Y.; Zhu, X.; Zhou, Y.; Hong, X. Preparation and characterization of polylactic acid/polyaniline/nanocrystalline cellulose nanocomposite films. Int. J. Biol. Macromol. 2020, 146, 1069–1075. [Google Scholar] [CrossRef]
- Han, Y.; Ding, J.; Zhang, J.T.; Li, Q.Y.; Yang, H.; Sun, T.; Li, H.H. Fabrication and characterization of polylactic acid coaxial antibacterial nanofibers embedded with cinnamaldehyde/tea polyphenol with food packaging potential. Int. J. Biol. Macromol. 2021, 184, 739–749. [Google Scholar] [CrossRef]
- Rhim, J.W.; Kim, J.H. Properties of poly (lactide)-coated paperboard for the use of 1-way paper cup. J. Food Sci. 2009, 74, 105–111. [Google Scholar] [CrossRef]
- Valerini, D.; Tammaro, L.; Villani, F.; Rizzo, A.; Caputo, I.; Paolella, G.; Vigliotta, G. Antibacterial Al-doped ZnO coatings on PLA films. J. Mater. Sci. 2020, 55, 4830–4847. [Google Scholar] [CrossRef]
- Rieger, K.A.; Schiffman, J.D. Electrospinning an essential oil: Cinnamaldehyde enhances the antimicrobial efficacy of chitosan/poly (Ethylene oxide) nanofibers. Carbohydr. Polym. 2014, 113, 561–568. [Google Scholar] [CrossRef]
- Khorsandi, A.; Ziaee, E.; Shad, E.; Razmjooei, M.; Eskandari, M.H.; Aminlari, M. Antibacterial effect of essential oils against spoilage bacteria from vacuum-packed cooked cured sausages. J. Food Prot. 2018, 81, 1386–1393. [Google Scholar] [CrossRef] [PubMed]
- Sun, X.; Narciso, J.; Wang, Z.; Ference, C.; Bai, J.; Zhou, K. Effects of chitosan-essential oil coatings on safety and quality of fresh blueberries. J. Food Sci. 2014, 79, 955–960. [Google Scholar] [CrossRef] [PubMed]
- Zhang, L.Y.; Huang, C.X.; Xu, Y.F.; Huang, H.H.; Zhao, H.; Wang, J.; Wang, S.F. Synthesis and characterization of antibacterial polylactic acid film incorporated with cinnamaldehyde inclusions for fruit packaging. Int. J. Biol. Macromol. 2020, 164, 4547–4555. [Google Scholar] [CrossRef]
- Faikoh, E.N.; Hong, Y.H.; Hu, S.Y. Liposome-encapsulated cinnamaldehyde enhances zebrafish (Danio rerio) immunity and survival when challenged with vibrio vulnificus and streptococcus agalactiae. Fish Shellfish Immunol. 2014, 38, 15–24. [Google Scholar] [CrossRef]
- Johny, A.K.; Darre, M.J.; Hoagland, T.A.; Schreiber, D.T.; Donoghue, A.M.; Donoghue, D.J.; Venkitanarayanan, K. Antibacterial effect of trans-cinnamaldehyde on Salmonella Enteritidis and Campylobacter jejuni in chicken drinking water. J. Appl. Poult. Res. 2008, 17, 490–497. [Google Scholar] [CrossRef]
- Pérez Córdoba, L.J.; Sobral, P.J.A. Physical and antioxidant properties of films based on gelatin, gelatin-chitosan or gelatin-sodium caseinate blends loaded with nanoemulsified active compounds. J. Food Eng. 2017, 213, 47–53. [Google Scholar] [CrossRef]
- Xu, F.; Zhang, J.; Guo, Z.; Chen, S.; Dong, H.; Zhang, X.; Qin, Y.; Yao, C. High-barrier, strong, and antibacterial paper fabricated by coating acetylated cellulose and cinnamaldehyde for food packaging. Cellulose 2021, 28, 4371–4384. [Google Scholar]
- Villegas, C.; Torres, A.; Rios, M.; Rojas, A.; Romero, J.; de Dicastillo, C.L.; Valenzuela, X.; Galotto, M.J.; Guarda, A. Supercritical impregnation of cinnamaldehyde into polylactic acid as a route to develop antibacterial food packaging materials. Food Res. Int. 2017, 99, 650–659. [Google Scholar] [CrossRef]
- Li, A.; Wang, G.; Zhang, Y.; Zhang, J.; He, W.; Ren, S.; Xu, Z.; Wang, J.; Ma, Y. Preparation methods and research progress of superhydrophobic paper. Co-ord. Chem. Rev. 2021, 449, 214207. [Google Scholar] [CrossRef]
- Chen, Y.; Gao, X.R.; Huang, H.D.; Xu, L.; Ji, X.; Zhong, G.J.; Lin, H.; Li, Z.M. Superhydrophobic, self-cleaning, and robust properties of oriented polylactide imparted by surface structuring. ACS Sustain. Chem. Eng. 2021, 9, 6296–6304. [Google Scholar] [CrossRef]
- Sbardella, F.; Rivilla, I.; Bavasso, I.; Russo, P.; Vitiello, L.; Tirillo, J.; Sarasini, F. Zinc oxide nanostructures and stearic acid as surface modifiers for flax fabrics in polylactic acid biocomposites. Int. J. Biol. Macromol. 2021, 177, 495–504. [Google Scholar] [CrossRef] [PubMed]
- Liu, S.; Cai, P.; Li, X.; Chen, L.; Li, L.; Li, B. Effect of film multi-scale structure on the water vapor permeability in hydroxypropyl starch (HPS)/Na-MMT nanocomposites. Carbohydr. Polym. 2016, 154, 186–193. [Google Scholar] [CrossRef] [PubMed]
- Tang, Z.; Fan, F.; Chu, Z.; Fan, C.; Qin, Y. Barrier properties and characterizations of poly (Lactic acid)/ZnO nanocomposites. Molecules 2020, 25, 1310. [Google Scholar] [CrossRef] [PubMed]
- He, M.; Xu, M.; Zhang, L. Controllable stearic acid crystal induced high hydrophobicity on cellulose film surface. ACS Appl. Mater. Interfaces 2013, 5, 585–591. [Google Scholar] [CrossRef] [PubMed]
- Seyedmehdi, S.-A.; Vrckovnik, R.; Amirfazli, A. Robust superhydrophobic coatings from modified siloxane resin. Surf. Innov. 2017, 5, 203–210. [Google Scholar] [CrossRef]
- Pamuła, E.; Błażewicz, M.; Paluszkiewicz, C.; Dobrzyński, P. FTIR study of degradation products of aliphatic polyesters–carbon fibres composites. J. Mol. Struct. 2001, 596, 69–75. [Google Scholar] [CrossRef]
- Wang, L.; Liu, F.; Jiang, Y.; Chai, Z.; Li, P.; Cheng, Y.; Jing, H.; Leng, X. Synergistic antimicrobial activities of natural essential oils with chitosan films. J. Agric. Food Chem. 2011, 59, 12411–12419. [Google Scholar] [CrossRef] [PubMed]
- Ahmed, J.; Arfat, Y.A.; Castro-Aguirre, E.; Auras, R. Mechanical, structural and thermal properties of Ag-Cu and ZnO reinforced polylactide nanocomposite films. Int. J. Biol. Macromol. 2016, 86, 885–892. [Google Scholar] [CrossRef]
- Leong, Y.W.; Abu Bakar, M.B.; Ishak, Z.M.; Ariffin, A.; Pukanszky, B. Comparision of the mechanical properties and interfacial interaction between talc, kaolin and calcium carbonate filled polypropylene composites. J. Appl. Polym. Sci. 2004, 91, 3315–3326. [Google Scholar] [CrossRef]
- Lu, J.; Sun, C.; Yang, K.; Wang, K.; Jiang, Y.; Tusiime, R.; Yang, Y.; Fan, F.; Sun, Z.; Liu, Y.; et al. Properties of polylactic acid reinforced by hydroxyapatite modified nanocellulose. Polymers 2019, 11, 1009. [Google Scholar] [CrossRef]
- Kanehashi, S.; Kusakabe, A.; Sato, S.; Nagai, K. Analysis of permeability; solubility and diffusivity of carbon dioxide; oxygen; and nitrogen in crystalline and liquid crystalline polymers. J. Membr. Sci. 2010, 365, 40–51. [Google Scholar] [CrossRef]
- Kakroodi, A.R.; Kazemi, Y.; Nofar, M.; Park, C.B. Tailoring poly (Lactic acid) for packaging applications via the production of fully bio-based in situ microfibrillar composite films. Chem. Eng. J. 2017, 308, 772–782. [Google Scholar] [CrossRef]
- Samantaray, P.K.; Ellingford, C.; Farris, S.; O’Sullivan, D.; Tan, B.; Sun, Z.; McNally, T.; Wan, C. Electron beam-mediated cross-linking of blown film-extruded biodegradable PGA/PBAT blends toward high toughness and low oxygen permeation. ACS Sustain. Chem. Eng. 2022, 10, 1267–1276. [Google Scholar] [CrossRef]
- Guzman-Puyol, S.; Hierrezuelo, J.; Benitez, J.J.; Tedeschi, G.; Porras-Vazquez, J.M.; Heredia, A.; Athanassiou, A.; Romero, D.; Heredia-Guerrero, J.A. Transparent, UV-blocking, and high barrier cellulose-based bioplastics with naringin as active food packaging materials. Int. J. Biol. Macromol. 2022, 209, 1985–1994. [Google Scholar] [CrossRef]
- Wang, F.; Wang, L.; Zhang, X.; Ma, S.; Zhao, Z. Study on the barrier properties and antibacterial properties of cellulose-based multilayer coated paperboard used for fast food packaging. Food Biosci. 2022, 46, 101398. [Google Scholar] [CrossRef]
- Valizadeh, S.; Naseri, M.; Babaei, S.; Hosseini, S.M.H.; Imani, A. Development of bioactive composite films from chitosan and carboxymethyl cellulose using glutaraldehyde, cinnamon essential oil and oleic acid. Int. J. Biol. Macromol. 2019, 134, 604–612. [Google Scholar] [CrossRef]
- Carson, C.F.; Mee, B.J.; Riley, T.V. Mechanism of action of melaleuca alternifolia (tea tree) oil on staphylococcus aureus determined by time-kill, lysis, leakage, and salt tolerance assays and electron microscopy. Antimicrob. Agents Chemother. 2002, 46, 1914–1920. [Google Scholar] [CrossRef]
- Zhang, X.; Wang, L.; Levänen, E. Superhydrophobic surfaces for the reduction of bacterial adhesion. RSC Adv. 2013, 3, 12003–12020. [Google Scholar] [CrossRef]
- Wang, W.; Zhou, Y.; Yang, L.; Yang, X.; Yao, Y.; Meng, Y.; Tang, B. Stimulus-responsive photonic crystals for advanced security. Adv. Funct. Mater. 2022, 2204744. [Google Scholar] [CrossRef]
- Ham-Pichavant, F.; Sèbe, G.; Pardon, P.; Coma, V. Fat resistance properties of chitosan-based paper packaging for food applications. Carbohydr. Polym. 2005, 61, 259–265. [Google Scholar] [CrossRef]

| Sample | Thickness (μm) | Grammage (g/m2) | Kit | OTR (cm3/m2·24 h·0.1 MPa) | WVP (g/m2·24 h·Pa) |
|---|---|---|---|---|---|
| CP | 32.7 | 30.64 | 0 | / | 1802.35 |
| PC | 47.3 | 42.32 | 12 | 143.237 | 315.21 |
| PC−SA | 52.6 | 45.45 | 12 | 79.315 | 265.11 |
| PC−SA/SiO2 | 54.6 | 45.49 | 12 | 57.942 | 206.95 |
| Sample | Other Substances | Thickness (μm) | Grammage (g/m2) | OTR (cm3/m2·24 h·0.1 MPa) | WVP (g/m2·24 h·Pa) | References |
|---|---|---|---|---|---|---|
| LDPE | / | 20–80 | / | 98–453 | 25 | [43] |
| HDPE | / | 20–80 | / | 26.3–98.5 | 5–62.5 | [43] |
| PTFE | / | 50 | / | 222–387 | 0.09–6 | [43] |
| PP | / | 20–60 | / | 35–377 | 6.7–10 | [43] |
| PGA/PBAT | GMA | 95.4–123 | / | 59.8–74.3 | 236.9–277.5 | [43] |
| Nanofiber film | PLA | / | / | / | 1029.36 | [17] |
| PLA | CIN | / | / | 3120 | 27.59 | [23] |
| Kraft paper | Acetylated cellulose | 284 | 90.2 | 2600 | 20.84 | [27] |
| Cellulose | Naringin | 70 | 308.8 | 55 | 3000 | [44] |
| PLA | CMCS/CMC | 505.8 | 309.2 | 924 | 166 | [45] |
| PLA/ZnONPs | CMCS/CMC | 505.8 | / | 406 | 72 | [45] |
| PC−SA/SiO2 | / | 54.6 | 45.49 | 57.942 | 206.95 | This work |
Publisher’s Note: MDPI stays neutral with regard to jurisdictional claims in published maps and institutional affiliations. |
© 2022 by the authors. Licensee MDPI, Basel, Switzerland. This article is an open access article distributed under the terms and conditions of the Creative Commons Attribution (CC BY) license (https://creativecommons.org/licenses/by/4.0/).
Share and Cite
Jiang, X.; Li, Q.; Li, X.; Meng, Y.; Ling, Z.; Ji, Z.; Chen, F. Preparation and Characterization of Degradable Cellulose−Based Paper with Superhydrophobic, Antibacterial, and Barrier Properties for Food Packaging. Int. J. Mol. Sci. 2022, 23, 11158. https://doi.org/10.3390/ijms231911158
Jiang X, Li Q, Li X, Meng Y, Ling Z, Ji Z, Chen F. Preparation and Characterization of Degradable Cellulose−Based Paper with Superhydrophobic, Antibacterial, and Barrier Properties for Food Packaging. International Journal of Molecular Sciences. 2022; 23(19):11158. https://doi.org/10.3390/ijms231911158
Chicago/Turabian StyleJiang, Xiaofan, Qiang Li, Xinting Li, Yao Meng, Zhe Ling, Zhe Ji, and Fushan Chen. 2022. "Preparation and Characterization of Degradable Cellulose−Based Paper with Superhydrophobic, Antibacterial, and Barrier Properties for Food Packaging" International Journal of Molecular Sciences 23, no. 19: 11158. https://doi.org/10.3390/ijms231911158
APA StyleJiang, X., Li, Q., Li, X., Meng, Y., Ling, Z., Ji, Z., & Chen, F. (2022). Preparation and Characterization of Degradable Cellulose−Based Paper with Superhydrophobic, Antibacterial, and Barrier Properties for Food Packaging. International Journal of Molecular Sciences, 23(19), 11158. https://doi.org/10.3390/ijms231911158

